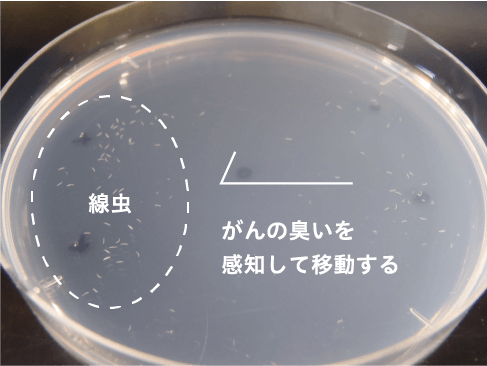

なぜ、医療にエンタテインメントが必要なのか。
エイベックス・ヘルスケアエンパワー合同会社 代表 保屋松 靖人
株式会社HIROTSUバイオサイエンス 代表取締役社長 広津 崇亮
虫の嗅覚を使った、新しいがん検査法。
- 保屋松
- 私の息子は横紋筋肉種という小児がんにかかりました。発見時には病気が進んでおり、医師からはステージ1~2であれば治る可能性が7割あると言われました。幸いにも、うちの子は最善の治療を受けることができ、元気に生活ができる状況になりましたが、「なぜ、がん検診を受けさせてあげられなかったのか」という悔いは残りました。広津先生の「N-NOSE」を知ったのは、そんな悶々としていた頃です。初めて知る方のためにも改めて教えていただけますか?
- 広津
- はい。まずN-NOSEとは、線虫という1mmほどの生き物を使ったがん検査のことです。線虫は、嗅覚が非常に優れていて、がんの臭いを検知することができるんですね。微量の物質でも嗅ぎ分けられます。
- 保屋松
- がんとは、臭いがあるものなのですか?
- 広津
- 体のいろいろな所から発しているようです。私はもともと線虫の嗅覚の研究者で、医療に応用しようとは考えていなかったのですが、がん探知犬の存在を知り、「犬にできるのなら、線虫ならもっとできるはず」と思い立ち、N-NOSEの開発に取り掛かりました。
- 保屋松
- どのように検査をするのでしょうか?
- 広津
- まず尿を一滴採取します。線虫は、がんの臭いを好み、健常者の尿の臭いを嫌います。検査では、線虫の入ったシャーレの中に尿を落として、それに寄って行くかどうかでがんを判別するんです。精度に関しては、95.8%という数字を示しました。既存の検査に比べると圧倒的なスコアです。
- 保屋松
- 私の息子は、治療を終えても、再発させないために定期検診に通っていたのですが、がんがまだ残っているかどうかが分からない不安な状態が続きました。N-NOSEはがんの初期段階も検知できるというのを聞き、実用化されたら非常に心強いと思いました。
- 広津
- N-NOSEは、再発をチェックするためにも使えるという結果が出てきています。理想的な使い方としては、一次スクリーニングといって、がん検査の一番最初に実施することです。まずN-NOSEで検査をして、異変が見つかれば、精密な検査をするという使い方ですね。
嗅覚は犬の1.5倍
線虫は、体調1mmという小さい体ながら、約1,200種もの嗅覚受容体を備えています。人間は約350種、犬は約 800種という数から比較してもその凄さは明快。
必要なのは、尿1滴
がん患者の尿には、がん特有の臭いを発する物質が微量に含まれています。その臭いを好む線虫の習性を利用するのがN-NOSEです。検査費用を低額に抑えることが可能。
精度は、95.8%
がんの有無を検査するN-NOSEの精度は、95.8%。従来の検査と比較すると、圧倒的な確率で検知。がん種を特定する以前の一次スクリーニングとして期待されています。
▶ N-NOSE について詳しくはこちら
▶ N-NOSE について詳しくはこちら精度が高くて、しかも安い。
- 保屋松
- 線虫の反応で識別するだけでいいのであれば、これまでの検査とコスト面でも変わってきますね?
- 広津
- 線虫は、自然界に存在するので、飼育コストはほぼ0円です。これまでがんを検出したければ、がん細胞が出している特有の物質を検知する必要がありました。しかし、ステージが浅くて微量しかない場合、それを検知するには高性能の機械を作らなくてはなりませんでした。となると、検査費も高くなります。精度が高くて安い、N-NOSEのような検査は、世界で初めてだと思います。
- 保屋松
- 現在、年間2,000人から2,500人の子供が小児がんにかかっています。親の立場としては、「もしかしたら、がんが見つかるかもしれない」という精度の検査のために、何万円もかけて、子供を半日病院に拘束するという気にはなかなかなれないと思うんです。
- 広津
- ですので、N-NOSEは子供でも受けられる。そこが優れた点です。小児がんって、「かかった方は運が悪かった」という病気に思われがちです。けれど、保屋松さんとお話ししているうちに、小児がんほど悲惨ながんはないと思うようになりました。自分の子が亡くなるなんて、想像しただけで辛すぎますから…。

保屋松 靖人 / 1998年エイベックス(株)入社。TRFやAAAなど、20年に渡り様々なアーティストのマネジメント業務に従事。自身の経験から小児がん基金のための一般社団法人設立及び、エンタテインメントを通じて社会貢献をしていくための合同会社「AVEX & HIROTSU BIO EMPOWER LLC.」を創立して代表に就任。
すごい技術だけじゃ、広まらない。
- 広津
- 日本は他の国と比べて、がん検診の受診率が低いんです。これを上げるために必要なのは、まず一つは画期的な技術。「痛い」「面倒くさい」「高い」検査だと受けてくれません。まずそこをクリアすること。でも、おそらくそれだけじゃ変わらない。啓発活動が大事だと思っています。もちろん、これまでも国が呼びかけてきたりもしましたが、「がん検診を受けよう」と能動的に動く人は少なかったんじゃないでしょうか。これからは、自分から受けようと思ってもらうことと、かつ若いうちから受けてもらうことが大切です。保屋松さんにお会いしたのは、どうすれば世の中の人たちが能動的にがん検診を受けてくれるのか、悩んでいる時期でした。
- 保屋松
- 私も、エンタテインメントに20年程携わってきた経験を活かして、小児がんに対して何かやれないかと考えていたんです。N-NOSEの存在を知った時、これこそが未来の子供たちを救う方法だと思いました。
- 広津
- 意気投合しましたね。
- 保屋松
- 早速広津さんには、a-nation(エイベックスが開催する夏の野外ライヴイベント)にお越しいただきました。
- 広津
- 若者たちが熱狂するのを見て、「これだったら上手い働きかけができる」と期待が高まりましたね。
- 保屋松
- エイベックスには、若年層に支持を得ているアーティストが多数います。彼らのようなインフルエンサー的な存在からがん検診を働きかけないと、若者たちは意識を変えて行動に移さないのではないかと思います。一方、諸外国では、社会貢献性の高い活動に積極的に参加するアーティストがいるのですが、日本はそうした活動に腰が重い風潮があります。私はそれも変えていきたいと思っていて。こうした活動こそエンタテインメントの存在意義なのではないかと感じているので、HIROTSUバイオサイエンスとエイベックスにとって、こんなに素晴らしい出会いはないですよね。

広津 崇亮 / 生物学者。線虫の嗅覚の研究を25年間行う。その過程で培ったノウハウを基盤に、線虫がん検査「N-NOSE」を発明。一刻も早い実用化と普及のために、大学教員の職を辞し、ベンチャー企業「HIROTSUバイオサイエンス」を創立して代表に就任。
エンタテインメントで、社会を救う。
- 保屋松
- AVEX & HIROTSU BIO EMPOWERがめざす未来について。広津さんはどんな将来像をお持ちですか?
- 広津
- まずN-NOSEを、大人だけじゃなく、学校の健康診断で子供がみんな受けている未来。早期発見ができるようになるので、がんが怖い病気じゃなくなります。
- 保屋松
- そうですね。早期発見ができるようになると、今、問題となっている医療費も抑えることができるはずです。社会に向けてもう一つ、私たちはEmpower Childrenを立ち上げましたね。こちらは、小児がんで苦しんでいる子供やそのご家族へ金銭的•人的支援をするための社団法人です。
- 広津
- 優れた抗がん剤などが出てきていますが、大抵、ものすごい値段がしますからね。
- 保屋松
- 小児がんになった子供とその親は、長期の入院や通院を強いられるので、金銭面や精神面で非常に負担がかかるものです。その方たちに、手を差し伸べられるような活動をしたいと思っています。チャリティーライヴなどで得た収益を、きちんと還元するための体制です。
- 広津
- そうですね。それとEmpower Childrenは、小児がん撲滅を図るプラットフォームのような場所になるといいですよね。私たちと同じ思いを持った企業が集まって、子供たちを支えて行く場に。集まった基金は、患者さんへの支援だけでなく、がんの治療法を研究している方の研究資金に充ててもらうこともしたいですね。
- 保屋松
- 広津先生の周りでも、世の中に広めるべき研究をされている方はいらっしゃいますか?
- 広津
- 山ほどいます。しかし、日本の研究機関は、そういう点が苦手で。お金を集められなくて頓挫してしまうということを、この国はずっと繰り返してきているんですよ。
- 保屋松
- N-NOSEのような優れた技術をひとつでも多く世に広めて、病気で苦しむ人たちを救っていきたいですね。


 お問い合わせはこちらから
お問い合わせはこちらから